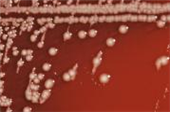

(세균) Salmonella arizona
-
- 작성자
- 최고관리자
-
- 조회
- 267
-
- 작성일
- 2020-02-07
(세균) Salmonella arizona
Salmonella enterica subsp.arizonae on a blood agar culture plate
출처:http://phil.cdc.gov/phil/details.aspID#15190, CDC
• 위 험 군 :제 2위험군
• 국내범주 :고위험병원체, 전략물자통제병원체
• 특 성 :Enterobacteriaceae과, 그람음성, 산소성, 막대균, 편모 있음, 운동성 있음, 포자형성 안함
병원성 및 감염증상
- 잠복기 : 매우 다양함. 노출 후 감염까지가 3개월 보고된 바 있으며, rattlesnake meat(방울뱀 고기)에 노출 후 6년 뒤 발병한 기록이 있음.
- 주로 파충류, 동물에 감염이 되고 사람 감염은 드묾. 사람감염은 악성종양, 장기이식, HIV감염 등 면역이 저하된 사람 및 7세 이하 어린이에게 주로 감염됨.
- 오염된 유제품 및 난 제품(egg product)으로 인한 위장염 발생.
치료 및 백신
- 치료 : ampicillin, chloramphenicol 등
- 백신 : -
실험실 생물안전정보
- 감염위해요소
- 감염 경로
- 일반 감염경로:오염된 식품(유제품, 난 제품) 섭취
- 실험자 감염경로: 배양액 등 감염성물질에 찔림 사고 및 섭취 - 감염량 : -
- 숙주 : 사람, 쥐, 오리, 개, 고양이, 가금류
- 실험실 획득감염: -
- 생물안전밀폐등급
- BL2 권장:감염성물질 및 병원체를 직접 취급하는 실험
- 개인보호장비 : 반드시 실험복, 장갑을 착용하고, 필요시 호흡보호장비 착용. 고농도, 혹은 대용량 배양액 조작은 생물안전작업대(BSC) 내에서 작업할 것을 권장, 주사바늘 및 날카로운 실험도구 사용 자제
- 소독 및 불활성화 : 1% sodium hypochlorite, 2% glutaraldehyde, 70% ethanol, 70% prophanol, 2% peracetic acid, 3~6% hydrogen peroxide, 2~5% phenol에 감수성 있음, 121℃에서 15분간 고압증기멸균 등
- 숙주 외 환경저항성:그늘진 양계장에서 최대 6개월, 알루미늄에서 5주, 물에서 9주, 플라스틱에서 11주, 고무 와 달걀껍질에서 12주, 나무 및 달걀 트레이, 먹이 상자에서 25주, 쓰레기에서 19주 생존 가능
- 폐기물 처리:감염성물질을 취급한 모든 폐기물은 고압증기멸균 등의 처리 후 의료폐기물로 처리
